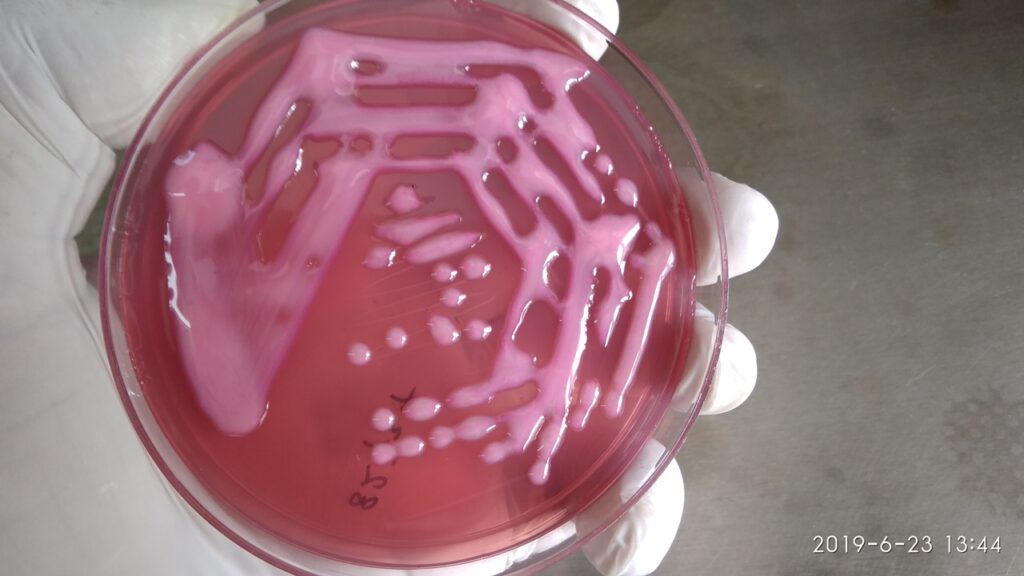

Saúde
Descoberta de nova superbactéria no Nordeste preocupa cientistas
Resistência bacteriana: Uma ameaça global em expansão
Uma descoberta alarmante marcou o ano de 2022: uma cepa da Klebsiella pneumoniae, resistente a todas as formas de tratamento antibiótico, foi identificada em uma paciente de 86 anos no Nordeste do Brasil. Infelizmente, a paciente não resistiu e veio a falecer apenas 24 horas após ser internada. Esta descoberta é um indício de uma preocupante tendência de aumento da resistência bacteriana que pode trazer consequências globais devastadoras.
Pesquisadores apoiados pela FAPESP analisaram a cepa e descobriram que ela já havia sido identificada em outras partes do mundo, como nos Estados Unidos, e está se espalhando pelo Brasil. Publicado na prestigiada revista The Lancet Microbe, o estudo gerou alerta entre a comunidade científica. Ele evidencia a capacidade destas bactérias em se adaptar rapidamente aos tratamentos existentes, ameaçando se tornar um problema crítico de saúde pública.
Como as Bactérias Adquirem Resistência?
A questão que intriga muitas pessoas é: como essas bactérias se tornam tão resistentes? Os microrganismos adquirem resistência principalmente por meio de mutações e pela troca de material genético com outras bactérias. Em ambientes hospitalares, onde o uso de antibióticos é intenso, essas mutações são mais frequentes.
Klebsiella pneumoniae: Uma Ameaça Atual?
A Klebsiella pneumoniae é uma bactéria versátil e adaptável. Em pessoas com imunidade comprometida, como pacientes em UTIs ou em tratamentos prolongados, ela pode causar infecções graves e potencialmente fatais. Com o aumento do uso de antibióticos durante a pandemia de Covid-19, sua resistência evoluiu rapidamente. Desta forma, não só persistiu, mas também aumentou sua presença em ambientes hospitalares.
Medidas de Contenção e Prevenção
Diante deste cenário preocupante, o que podemos fazer para combater a resistência bacteriana? Primeiramente, é essencial que hospitais e profissionais de saúde sigam protocolos rigorosos de higiene e notifiquem casos de bactérias multirresistentes às autoridades de saúde. Além disso, a prescrição racional de antibióticos é crucial para reduzir o surgimento de novas cepas resistentes.
Recomendações para Pacientes e Profissionais de Saúde
- Isolamento: Pacientes com infecções bacterianas resistentes devem ser imediatamente isolados.
- Higiene Rigorosa: Práticas de higiene devem ser seguidas à risca para evitar a disseminação da bactéria.
- Prescrição Racional de Antibióticos: Evitar o uso excessivo de antibióticos e seguir rigorosamente as instruções médicas.
- Conclusão dos Tratamentos: Completar o ciclo completo do antibiótico, mesmo que os sintomas desapareçam antes do fim do tratamento.
Por Que a Pandemia Aumentou a Resistência Bacteriana?
Durante a pandemia de Covid-19, o uso de antibióticos cresceu significativamente, muitas vezes de forma inadequada, para tratar ou prevenir infecções secundárias. Isso resultou em um salto na resistência de bactérias como a Klebsiella pneumoniae, exigindo ainda mais atenção das autoridades de saúde e dos profissionais da área.
A plataforma One Health Brazilian Resistance, coordenada pelo professor Nilton Lincopan do ICB-USP, desempenha um papel crucial no monitoramento e na pesquisa de bactérias resistentes. Juntamente com outras instituições e agências, ela trabalha no desenvolvimento de novas estratégias para conter essa ameaça crescente.
A resistência bacteriana é uma preocupação global e requer esforços conjuntos de todos os setores envolvidos. Somente através da conscientização, do investimento em pesquisa e da adoção de práticas de saúde responsáveis, conseguiremos enfrentar esta ameaça e garantir um futuro seguro em termos de saúde pública.







